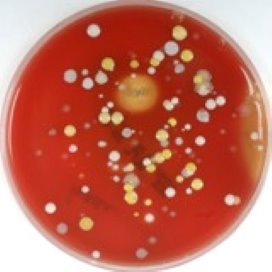

Met “vieze foto’s” maakt het Catharina Ziekenhuis de verpleegkundigen bewuster over handhygiëne.
Ziekenhuishygiënist Ingeborg Tol heeft het project met de foto’s opgezet, omdat er nog veel fabels bleken te heersen onder verpleegkundigen. Het Eindhovense ziekenhuis kampte vorig jaar met veel resistente bacteriën. ‘De uitbraak was een aanwijzing dat er toch meer voorlichting nodig was’, zegt Tol in Nursing.
Handdesinfectie
De foto’s zijn onderdeel van het project ‘Bacteriën, laat ze niet meeliften’. Het project benadrukt dat handen alleen gewassen hoeven te worden bij zichtbare verontreiniging, en dat handdesinfectie met alcohol belangrijker is voor tussendoor. ‘Vooral oudere verpleegkundigen blijken desondanks te zweren bij wassen met zeep, in plaats van desinfecteren’, zegt Tol.
Geef je reactie
Om te kunnen reageren moet je inlogd zijn. Inloggen Ik heb nog geen account